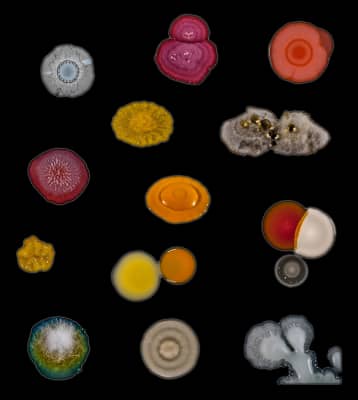

Scott Chimileski
| Use attributes for filter ! | |
| Books | Life at the Edge of Sight: A Photographic Exploration of the Microbial World |
|---|---|
| Affiliations | Marine Biological Laboratory |
| Woods Hole | |
| Interests | Biofilms |
| Imaging | |
| Human Microbiome | |
| Microbial Interactions | |
| Archaeal And Bacterial Physiology | |
| Date of Reg. | |
| Date of Upd. | |
| ID | 4348535 |
About Scott Chimileski
Scott Chimileski is a science photographer, imaging specialist, and Research Scientist in the Bay Paul Center at the Marine Biological Laboratory (MBL) in Woods Hole, Massachusetts.